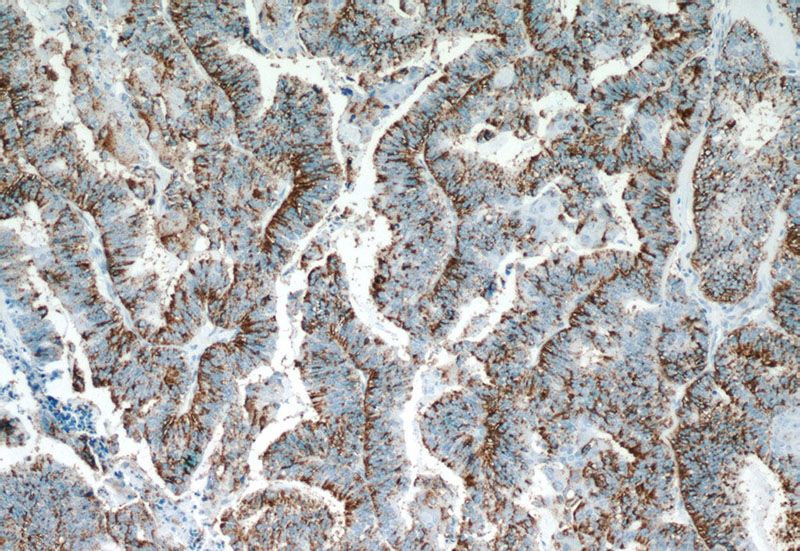
Immunohistochemistry of paraffin-embedded human ovary tumor tissue slide using Catalog No:114222(SERPINA5 Antibody) at dilution of 1:50 (under 10x lens)
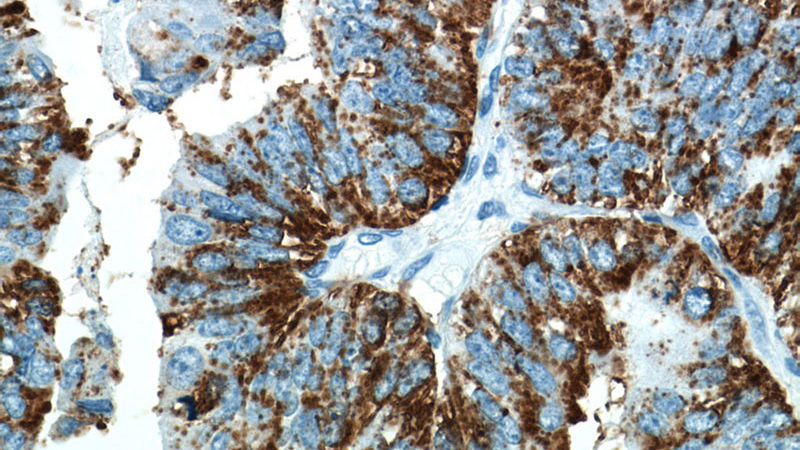
Immunohistochemistry of paraffin-embedded human ovary tumor tissue slide using Catalog No:114222(SERPINA5 Antibody) at dilution of 1:50 (under 40x lens)

-
Product Name
Protein C inhibitor antibody
- Documents
-
Description
Protein C inhibitor Rabbit Polyclonal antibody. Positive WB detected in HepG2 cells, A549 cells, HeLa cells, Jurkat cells, L02 cells, PC-3 cells. Positive IF detected in HepG2 cells. Positive IHC detected in human ovary tumor tissue, human breast cancer tissue, human testis tissue. Observed molecular weight by Western-blot: 46 kDa
-
Tested applications
ELISA, WB, IHC, IF
-
Species reactivity
Human; other species not tested.
-
Alternative names
PAI3 antibody; PCI antibody; PLANH3 antibody; PROCI antibody; Protein C inhibitor antibody; SERPINA5 antibody
-
Isotype
Rabbit IgG
-
Preparation
This antibody was obtained by immunization of Protein C inhibitor recombinant protein (Accession Number: NM_000624). Purification method: Antigen affinity purified.
-
Clonality
Polyclonal
-
Formulation
PBS with 0.1% sodium azide and 50% glycerol pH 7.3.
-
Storage instructions
Store at -20℃. DO NOT ALIQUOT
-
Applications
Recommended Dilution:
WB: 1:500-1:5000
IHC: 1:20-1:200
IF: 1:50-1:500
-
Validations

HepG2 cells were subjected to SDS PAGE followed by western blot with Catalog No:114222(SERPINA5 antibody) at dilution of 1:1000
Immunohistochemistry of paraffin-embedded human ovary tumor tissue slide using Catalog No:114222(SERPINA5 Antibody) at dilution of 1:50 (under 10x lens)
Immunohistochemistry of paraffin-embedded human ovary tumor tissue slide using Catalog No:114222(SERPINA5 Antibody) at dilution of 1:50 (under 40x lens)

Immunofluorescent analysis of (10% Formaldehyde) fixed HepG2 cells using Catalog No:114222(SERPINA5 Antibody) at dilution of 1:50 and Alexa Fluor 488-congugated AffiniPure Goat Anti-Rabbit IgG(H+L)
-
Background
SERPINA5 (also called Protein C Inhibitor, PCI ) is a serpin type of serine protease inhibitor that is found in many tissues and fluids in human, including blood plasma, seminal plasma and urine. PCI found in blood originates from the liver and is capable of inhibiting several serine proteases involved in the regulation of coagulation and fibrinolysis, including activated protein C, thrombin, factor Xa, various kallikreins and plasminogen activators. PCI has been found to have antimicrobial and antitumor properties and thus appears to be a multi-functional protein.
-
References
- Rodriguez FJ, Giannini C, Asmann YW. Gene expression profiling of NF-1-associated and sporadic pilocytic astrocytoma identifies aldehyde dehydrogenase 1 family member L1 (ALDH1L1) as an underexpressed candidate biomarker in aggressive subtypes. Journal of neuropathology and experimental neurology. 67(12):1194-204. 2008.
- Bijsmans IT, Smits KM, de Graeff P. Loss of SerpinA5 protein expression is associated with advanced-stage serous ovarian tumors. Modern pathology : an official journal of the United States and Canadian Academy of Pathology, Inc. 24(3):463-70. 2011.
Related Products / Services
Please note: All products are "FOR RESEARCH USE ONLY AND ARE NOT INTENDED FOR DIAGNOSTIC OR THERAPEUTIC USE"
